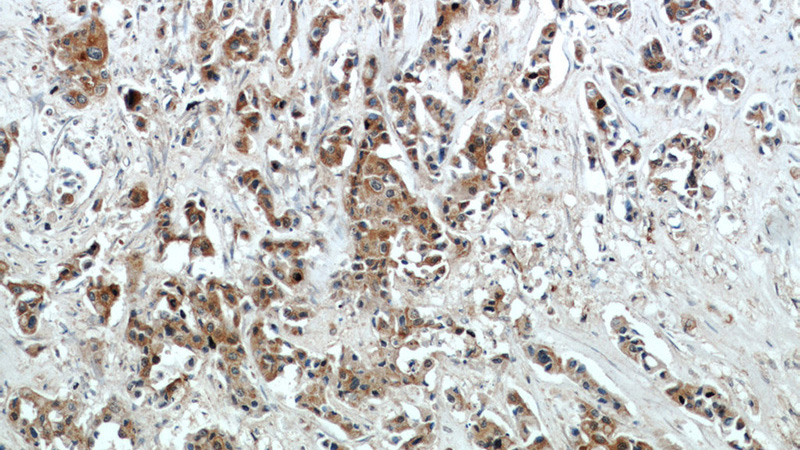
Immunohistochemical of paraffin-embedded human breast cancer using Catalog No:109994(DLK1 antibody) at dilution of 1:50 (under 10x lens)
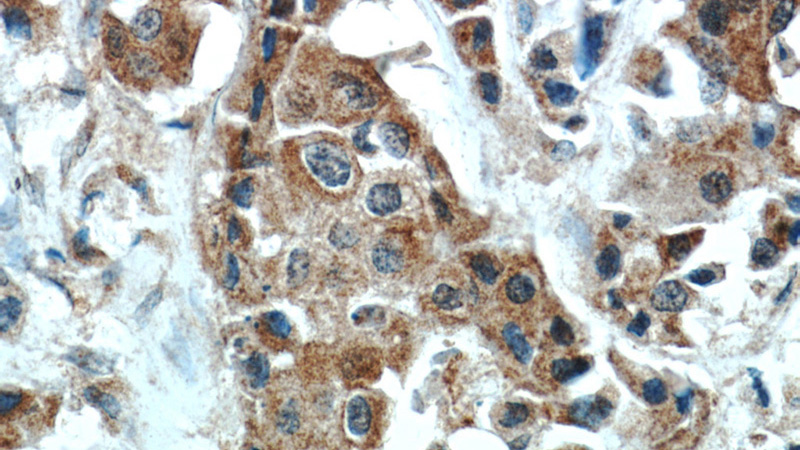
Immunohistochemical of paraffin-embedded human breast cancer using Catalog No:109994(DLK1 antibody) at dilution of 1:50 (under 40x lens)

-
Product Name
DLK1 antibody
- Documents
-
Description
DLK1 Rabbit Polyclonal antibody. Positive IHC detected in human breast cancer tissue. Positive WB detected in mouse placenta tissue, A549 cells, human placenta tissue, MCF7 cells, mouse brain tissue, mouse ovary tissue. Observed molecular weight by Western-blot: 45-60kd
-
Tested applications
ELISA, WB, IHC
-
Species reactivity
Human,Mouse,Rat; other species not tested.
-
Alternative names
DLK antibody; DLK 1 antibody; DLK1 antibody; FA1 antibody; pG2 antibody; Pref 1 antibody; PREF1 antibody; Protein delta homolog 1 antibody; ZOG antibody
-
Isotype
Rabbit IgG
-
Preparation
This antibody was obtained by immunization of DLK1 recombinant protein (Accession Number: NM_003836). Purification method: Antigen affinity purified.
-
Clonality
Polyclonal
-
Formulation
PBS with 0.1% sodium azide and 50% glycerol pH 7.3.
-
Storage instructions
Store at -20℃. DO NOT ALIQUOT
-
Applications
Recommended Dilution:
WB: 1:200-1:2000
IHC: 1:20-1:200
-
Validations

mouse placenta tissue were subjected to SDS PAGE followed by western blot with Catalog No:109994(DLK1 antibody) at dilution of 1:1000
Immunohistochemical of paraffin-embedded human breast cancer using Catalog No:109994(DLK1 antibody) at dilution of 1:50 (under 10x lens)
Immunohistochemical of paraffin-embedded human breast cancer using Catalog No:109994(DLK1 antibody) at dilution of 1:50 (under 40x lens)
-
Background
DLK1, also named PREF1, FA1, or pG2, is a transmembrane protein belonging to the epidermal growth factor (EGF)-like superfamily (PMID: 8095043). It contains six EGF-like repeats in the extracellular region. DLK1 is abundant in preadipocytes and regulate adipocyte differentiation negatively (PMID: 8500166). Deficiency of DLK1 gives rise to growth retardation and accelerated adiposity in mouse model. Expression of DLK1 is found in tumors with neuroendocrine features that implies DLK1 may be involved in neuroendocrine differentiation (PMID: 8095043). It has been reported overexpression of DLK1 could lead to the development of metabolic abnormalities by impairment of adipocyte function in mice (PMID: 12588883). The gene of DLK1 maps to chromosome 14q32, and encodes a 383-amino acid protein with a calculated molecular mass of 41 kDa. In preadipocytes, multiple discrete forms of DLK1 protein of 45-60 kDa are present, owing in part to N-linked glycosylation (PMID: 8500166).
-
References
- Li L, Tan J, Zhang Y. DLK1 promotes lung cancer cell invasion through upregulation of MMP9 expression depending on Notch signaling. PloS one. 9(3):e91509. 2014.
- Tao J, Calvisi DF, Ranganathan S. Activation of β-catenin and Yap1 in human hepatoblastoma and induction of hepatocarcinogenesis in mice. Gastroenterology. 147(3):690-701. 2014.
- Ayuso M, Óvilo C, Rodríguez-Bertos A. Dietary vitamin A restriction affects adipocyte differentiation and fatty acid composition of intramuscular fat in Iberian pigs. Meat science. 108:9-16. 2015.
- Zhou X, Li D, Yin J. CLA differently regulates adipogenesis in stromal vascular cells from porcine subcutaneous adipose and skeletal muscle. Journal of lipid research. 48(8):1701-9. 2007.
- da Rocha ST, Charalambous M, Lin SP. Gene dosage effects of the imprinted delta-like homologue 1 (dlk1/pref1) in development: implications for the evolution of imprinting. PLoS genetics. 5(2):e1000392. 2009.
- Keophiphath M, Achard V, Henegar C, Rouault C, Clément K, Lacasa D. Macrophage-secreted factors promote a profibrotic phenotype in human preadipocytes. Molecular endocrinology (Baltimore, Md.). 23(1):11-24. 2009.
- Kagami M, Matsuoka K, Nagai T. Paternal uniparental disomy 14 and related disorders: placental gene expression analyses and histological examinations. Epigenetics. 7(10):1142-50. 2012.
- Sone M, Nishikawa Y, Nagahama Y. Recovery of mature hepatocytic phenotype following bile ductular transdifferentiation of rat hepatocytes in vitro. The American journal of pathology. 181(6):2094-104. 2012.
Related Products / Services
Please note: All products are "FOR RESEARCH USE ONLY AND ARE NOT INTENDED FOR DIAGNOSTIC OR THERAPEUTIC USE"
